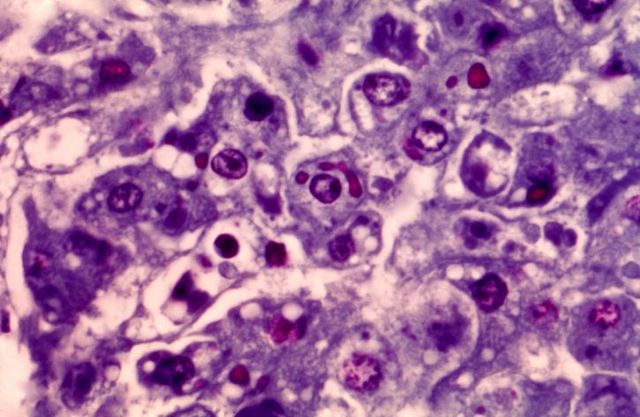
Scientists discover how to use human skin cells to create embryonic stem cells.

-
-
-
-
-
-
Middle Ages
-
Middle ages
-
-
-
-
-
-
-
-
-
-
-
-
-
-
-
-
-
-
-
-
-
Looking for a timeline maker?
Create timelines for projects, roadmaps, history, lessons, legal cases, and stories with Timetoast. Timetoast is a timeline maker for work, school, research, and stories.